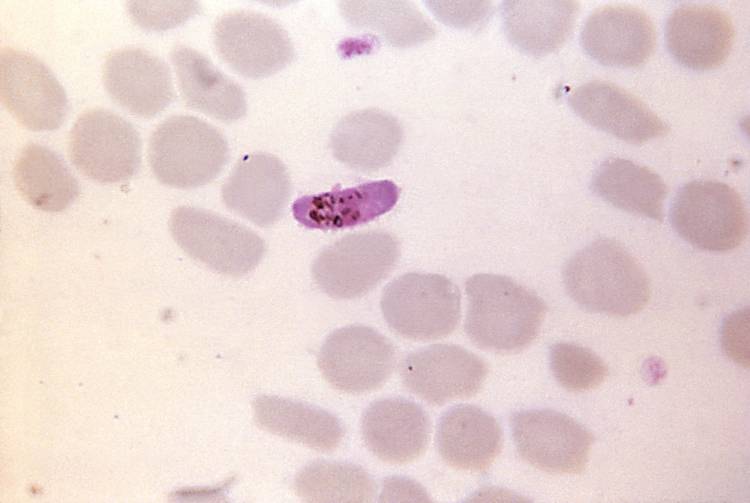
Microgamétocytes de Plasmodium falciparum

Retour à la médiathèque
Microgamétocytes de Plasmodium falciparum